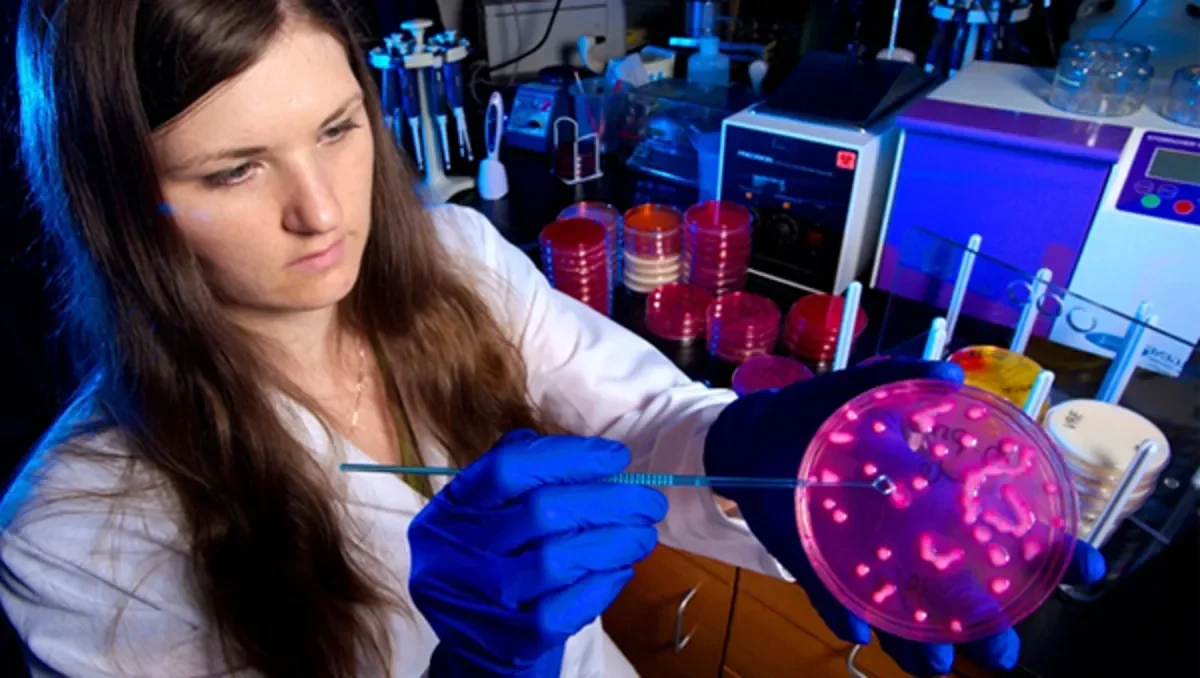

Preventable Bug-Spread Deaths in Infants
An internal investigation at Bradford Royal Infirmary revealed that the deaths of two premature babies in the neonatal intensive care unit during a bacterial outbreak in November 2021 could have been prevented. Lapses in hygiene practices allowed the drug-resistant Klebsiella pneumoniae to spread, infecting five other infants. The hospital has since implemented new infection control measures and increased staffing and training. The affected families have initiated legal action, feeling betrayed by the hospital's failure to prevent the outbreak.